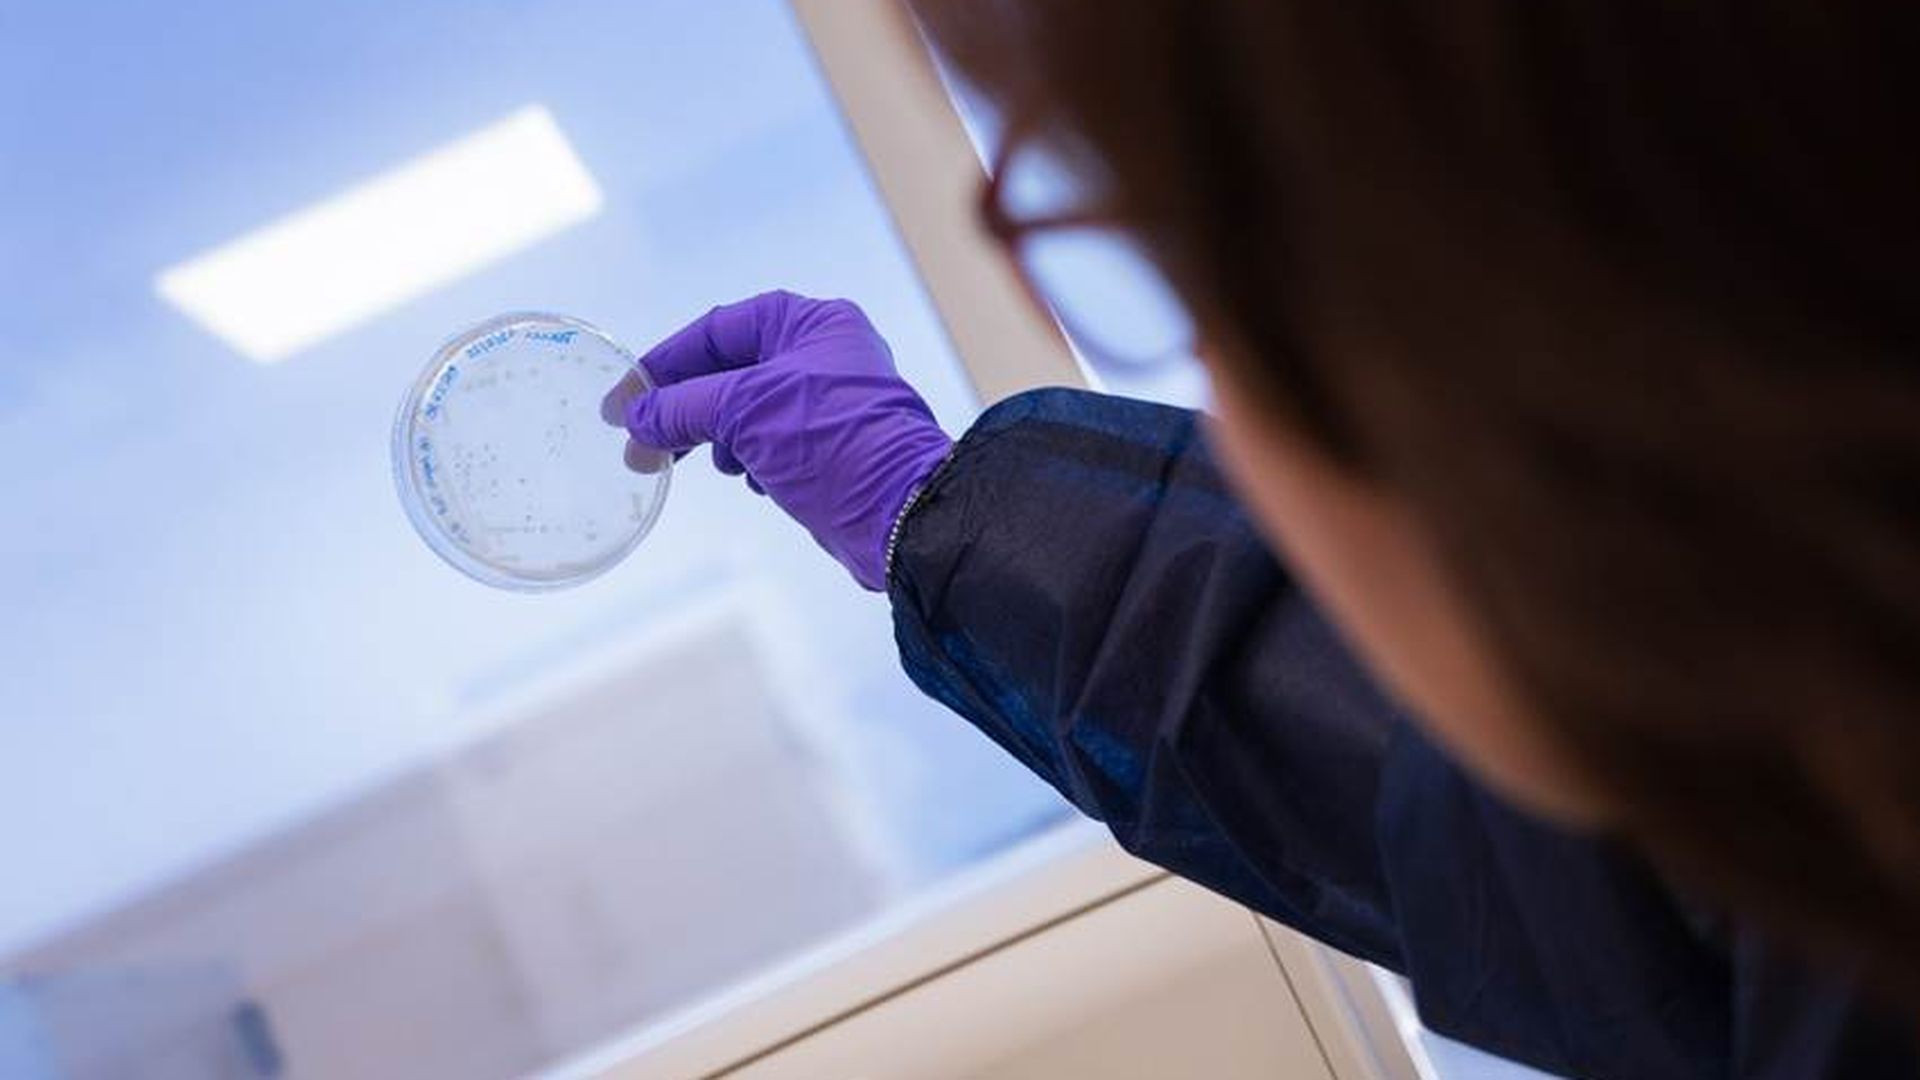

Un anticuerpo reduce el daño celular causado por la piocianina y abre una nueva vía contra infecciones resistentes
Un estudio in vitro demuestra que un anticuerpo reduce el daño celular causado por la piocianina y abre la puerta a nuevas terapias contra infecciones bacterianas resistentes
Más allá de las bebidas energéticas: los alimentos y bebidas con alto contenido en cafeína y azúcar que afectan a la salud
El Instituto de Química Avanzada de Cataluña del CSIC ha creado un anticuerpo 'in vitro' que neutraliza el daño de la bacteria Pseudomonas aeruginosa, presente en hospitales y considerada peligrosa por su resistencia a casi todos los antibióticos por la OMS, en el sistema inmune.
Publicado en la revista científica 'ACS Pharmacology and Translational Science' el trabajo no se centra en destruir la bacteria, sino en inhibir la toxina piocianina que produce, que mata las células del sistema inmune y altera la respuesta inflamatoria del organismo.
Esta estrategia "antivirulencia" evita la resistencia a los antibióticos
Esto es algo especialmente relevante al tratarse de uno de los patógenos más preocupantes a nivel global por su capacidad de resistencia a la mayoría de antibióticos disponibles.
Con este objetivo, las investigadoras del IQAC desarrollaron en ratones un anticuerpo monoclonal, una proteína generada en el laboratorio y que es fácil de bloquear, denominado mAb122, diseñado para unirse específicamente a la piocianina e impedir su acción.
Un anticuerpo contra la piocianina: una nueva vía terapéutica
El anticuerpo fue expuesto a distintas concentraciones de la toxina, y los resultados confirmaron que reduce el daño celular provocado por la piocianina, aumentando de forma significativa la supervivencia de las células.
Aunque todavía falta evaluar su eficacia en organismos vivos, el estudio in vitro plantea un enfoque terapéutico innovador para frenar infecciones graves sin incrementar el uso de antibióticos, un punto crítico en el contexto actual de resistencias bacterianas.
La investigadora del IQAC-CSIC y autora del estudio, Lluïsa Vilaplana, subraya la urgencia de abordar este tipo de bacterias, ya que su resistencia a los antibióticos es responsable de miles de muertes, especialmente en pacientes vulnerables.
“La alta adaptabilidad de esta bacteria ha impulsado el desarrollo de nuevas estrategias terapéuticas para reducir las cepas multirresistentes y minimizar la progresión de la infección”, explica Vilaplana.
